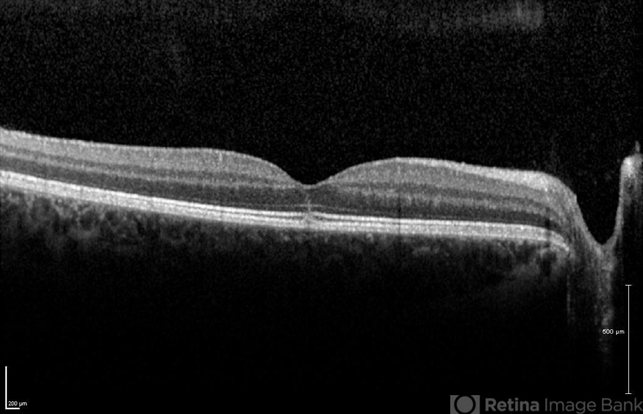

-
By Theodore Leng, MD, MS, FASRS
Byers Eye Institute at Stanford University School of Medicine - Uploaded on Mar 1, 2013.
- Last modified by Theodore Leng, MD, MS, FASRS on Jun 5, 2013.
- Reviewed by Caroline Bozell
- Rating
- Appears in
- Solar Retinopathy
- Condition/keywords
- solar retinopathy
- Photographer
- Erich Hagan
- Imaging device
-
Optical coherence tomography system
Heidelberg - Description
- OCT scan of a 15-year-old male with solar retinopathy after staring directly at a solar eclipse. Note the hyperreflectivity in the foveola.

Initializing download.
Initializing download.







